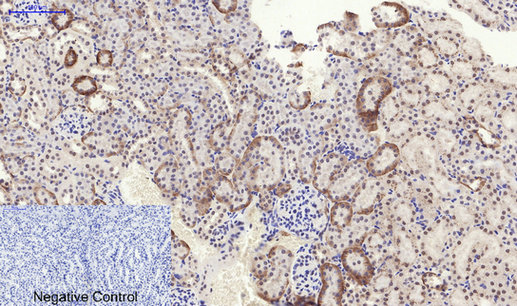

别名:EIF2AK3; PEK; PERK; Eukaryotic translation initiation factor 2-alpha kinase 3; PRKR-like endoplasmic reticulum kinase; Pancreatic eIF2-alpha kinase; HsPEK应用:WB,IHC,ICC
反应种属:Human,Mouse,Rat
规格:50μl/100μl
| Description |
|---|
| Metabolic-stress sensing protein kinase that phosphorylates the alpha subunit of eukaryotic translation initiation factor 2 (eIF-2-alpha/EIF2S1) on ‘Ser-52’ during the unfolded protein response (UPR) and in response to low amino acid availability. Converts phosphorylated eIF-2-alpha/EIF2S1 either in a global protein synthesis inhibitor, leading to a reduced overall utilization of amino acids, or to a translation initiation activator of specific mRNAs, such as the transcriptional activator ATF4, and hence allowing ATF4-mediated reprogramming of amino acid biosynthetic gene expression to alleviate nutrient depletion. Serves as a critical effector of unfolded protein response (UPR)-induced G1 growth arrest due to the loss of cyclin-D1 (CCND1). Involved in control of mitochondrial morphology and function. |
| Specification | |
|---|---|
| Aliases | EIF2AK3; PEK; PERK; Eukaryotic translation initiation factor 2-alpha kinase 3; PRKR-like endoplasmic reticulum kinase; Pancreatic eIF2-alpha kinase; HsPEK |
| Entrez GeneID | 9451 |
| Swissprot | Q9NZJ5 |
| WB Predicted band size | Calculated MW: 125 kDa; Observed MW: 130 kDa |
| Host/Isotype | Rabbit IgG |
| Storage | Store at 4°C short term. Aliquot and store at -20°C long term. Avoid freeze/thaw cycles. |
| Species Reactivity | Human,Mouse,Rat |
| Immunogen | The antiserum was produced against synthesized peptide derived from human PEK/PERK around the phosphorylation site of Thr982. AA range:947-996 |
| Formulation | Liquid in PBS containing 50% glycerol, 0.5% BSA and 0.02% sodium azide, pH 7.3. |
| Application | |
|---|---|
| WB | 1/500-1/1000 |
| IHC | 1/50-1/100 |
| ICC | 1/50-1/200 |
| ELISA | 1/10000 |
![]() |
Western blot analysis of Phospho-PERK (Thr982) in A453, AD293, Hela lysates using Phospho-PERK (Thr982) antibody. |
![]() |
Immunohistochemistry analysis of paraffin-embedded mouse kidney tissue using Phospho-PERK (Thr982) antibody High-pressure and temperature Sodium Citrate pH 6.0 was used for antigen retrieval. |
![]() |
Immunohistochemistry analysis of paraffin-embedded rat lung tissue using Phospho-PERK (Thr982) antibody.High-pressure and temperature Sodium Citrate pH 6.0 was used for antigen retrieval. |
本公司的所有产品仅用于科学研究或者工业应用等非医疗目的,不可用于人类或动物的临床诊断或治疗,非药用,非食用。
暂无评论
本公司的所有产品仅用于科学研究或者工业应用等非医疗目的,不可用于人类或动物的临床诊断或治疗,非药用,非食用。
中文

发表回复